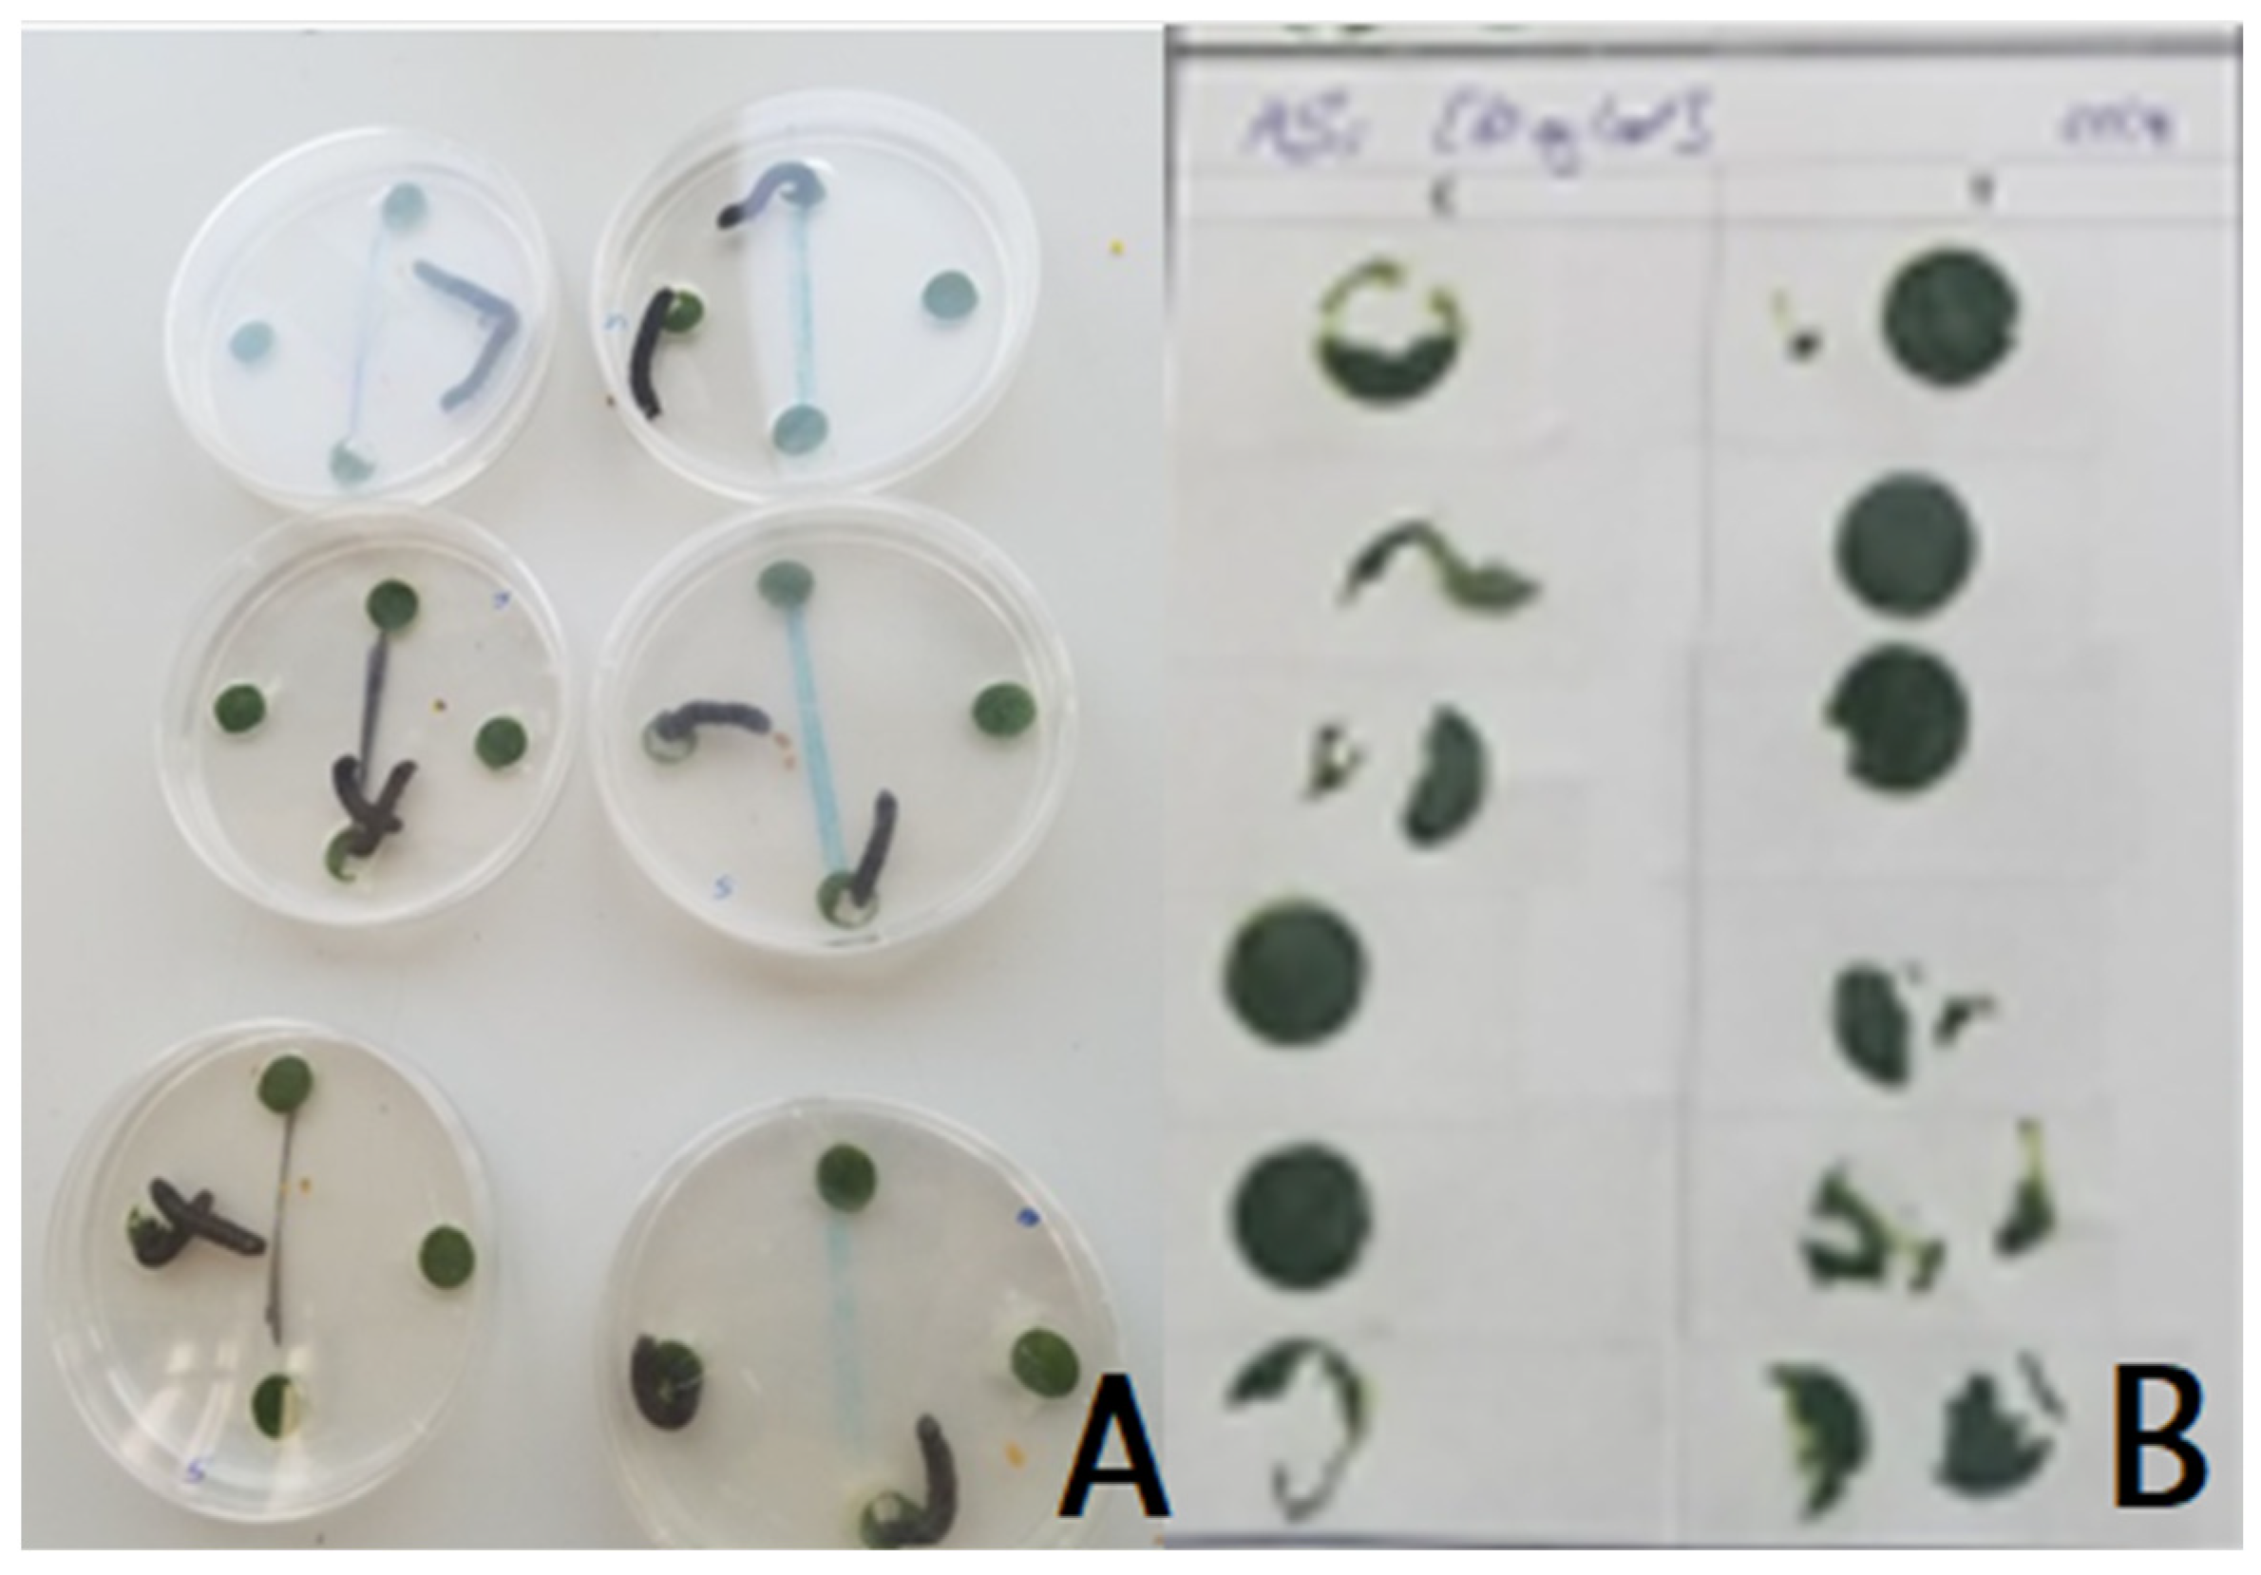
Blsf 30 00025 g001

Potential of Achyrocline satureioides Ethanolic Extract in the Control of Spodoptera littoralis †
Abstract
1. Introduction
2. Methodology
2.1. Plant Material
2.2. S. littoralis Larvae Obtention
2.3. Choice Feeding Assay
3. Results and Discussion
4. Conclusions
Author Contributions
Funding
Institutional Review Board Statement
Informed Consent Statement
Data Availability Statement
Conflicts of Interest
References
- Food and Agriculture Organization of the United Nations. The State of Food and Agriculture. 2021. Available online: http://www.fao.org/3/cb4476en/cb4476en.pdf (accessed on 1 April 2024).
- Babin, D. Protected Areas: Combining Biodiversity Conservation and Sustainable Development: Foundations and Recommendations for a Development Cooperation Strategy on Protected Area Management; Institut Français de la Biodiversité: Vincennes, France, 2013. [Google Scholar]
- Rodrigues, J.S.; De Castro, R.M.; Da Silva, M.G.G.; Da Silva, D.A. Atividade inseticida de extratos vegetais e seletividade a insetos benéficos. Rev. Semiárido De Visu 2017, 5, 138–148. [Google Scholar] [CrossRef]
- Carlos, L.-V. Species accounts of 100 of the Most invasive alien species in Europe. In Handbook of Alien Species in Europe; Springer Science: Berlin/Heidelberg, Germany, 2008; pp. 269–374. [Google Scholar]
- Salama, H.S.; Dimetry, N.Z.; Salem, S.A. On the host preference and biology of the cotton leaf worm Spodoptera littoralis Bois. Z. Für Angew. Entomol. 1971, 67, 261–266. [Google Scholar] [CrossRef]
- Hawkins, N.J.; Bass, C.; Dixon, A.; Neve, P. The evolutionary origins of pesticide resistance. Biol. Rev. 2019, 94, 135–155. [Google Scholar] [CrossRef] [PubMed]
- Kranthi, K.R.; Jadhav, D.R.; Kranthi, S.; Wanjari, R.R.; Ali, S.S.; Russell, D.A. Insecticide resistance in five major insect pests of cotton in India. Crop Prot. 2002, 21, 449–460. [Google Scholar] [CrossRef]
- Fantatto, R.R.; Gainza, Y.A.; Figueiredo, A.; Sorrechia, R.; Chagas, A.C.D.S.; Pietro, R.C.L.R. The association of extracts of Achyrocline satureioides and the fungus Beauveria bassiana against the tick Rhipicephalus microplus. Exp. Appl. Acarol. 2022, 87, 351–363. [Google Scholar] [CrossRef] [PubMed]
- Fantatto, R.R.; de Souza Chagas, A.C.; Gainza, Y.A.; Politi, F.A.S.; de Souza Mesquita, L.M.; Vilegas, W.; Bizzo, H.R.; Montanari, Í., Jr.; Pietro, R.C.L.R. Acaricidal and anthelmintic action of ethanolic extract and essential oil of Achyrocline satureioides. Exp. Parasitol. 2022, 236, 108252. [Google Scholar] [CrossRef] [PubMed]
- Bentley, M.D.; Leonard, D.E.; Stoddard, W.F.; Zalkow, L.H. Pyrrolizidine alkaloids as larval feeding deterrents for spruce budworm, Choristoneura fumiferana (Lepidoptera: Tortricidae). Ann. Entomol. Soc. Am. 1984, 77, 393–397. [Google Scholar] [CrossRef]
- Reina, M.; González-Coloma, A.; Gutiérrez, C.; Cabrera, R.; Rodríguez, M.L.; Fajardo, V.; Villarroel, L. Defensive chemistry of Senecio miser. J. Nat. Prod. 2001, 64, 6–11. [Google Scholar] [CrossRef] [PubMed]
- Hussein, H.S.; Salem, M.Z.; Soliman, A.M.; Eldesouky, S.E. Comparative study of three plant-derived extracts as new management strategies against Spodoptera littoralis (Boisd.) (Lepidoptera: Noctuidae). Sci. Rep. 2023, 13, 3542. [Google Scholar] [CrossRef] [PubMed]
- Salgueiro, A.C.; Folmer, V.; da Rosa, H.S.; Costa, M.T.; Boligon, A.A.; Paula, F.R.; Roos, D.H.; Puntel, G.O. In vitro and in silico antioxidant and toxicological activities of Achyrocline satureioides. J. Ethnopharmacol. 2016, 194, 6–14. [Google Scholar] [CrossRef] [PubMed]
- Tošović, J. Spectroscopic features of caffeic acid: Theoretical study. Kragujev. J. Sci. 2017, 39, 99–108. [Google Scholar] [CrossRef]
- Padial, I.M.P.M.; Souza, S.A.D.; Malaquias, J.B.; Cardoso, C.A.L.; Pachú, J.K.D.S.; Fioratti, C.A.G.; Mussury, R.M. Leaf Extracts of Miconia albicans (Sw.) Triana (Melastomataceae) Prevent the Feeding and Oviposition of Plutella xylostella (Linnaeus, 1758) (Lepidoptera: Plutellidae). Agronomy 2023, 13, 890. [Google Scholar] [CrossRef]
- Sayed, R.A.; Mahfouz, H.M.; Ali, M.M.; ElBassiony, M.N. Insecticidal properties of some plant extracts against cotton leafworm Spodoptera littoralis (BOISD). Sinai J. Appl. Sci. 2017, 6, 111–120. [Google Scholar] [CrossRef][Green Version]
Disclaimer/Publisher’s Note: The statements, opinions and data contained in all publications are solely those of the individual author(s) and contributor(s) and not of MDPI and/or the editor(s). MDPI and/or the editor(s) disclaim responsibility for any injury to people or property resulting from any ideas, methods, instructions or products referred to in the content. |
© 2024 by the authors. Licensee MDPI, Basel, Switzerland. This article is an open access article distributed under the terms and conditions of the Creative Commons Attribution (CC BY) license (https://creativecommons.org/licenses/by/4.0/).
Share and Cite
Fantatto, R.R.; Pietro, R.C.L.R. Potential of Achyrocline satureioides Ethanolic Extract in the Control of Spodoptera littoralis. Biol. Life Sci. Forum 2024, 30, 25. https://doi.org/10.3390/IOCAG2023-17338
Fantatto RR, Pietro RCLR. Potential of Achyrocline satureioides Ethanolic Extract in the Control of Spodoptera littoralis. Biology and Life Sciences Forum. 2024; 30(1):25. https://doi.org/10.3390/IOCAG2023-17338
Chicago/Turabian StyleFantatto, Rafaela Regina, and Rosemeire Cristina Linhari Rodrigues Pietro. 2024. "Potential of Achyrocline satureioides Ethanolic Extract in the Control of Spodoptera littoralis" Biology and Life Sciences Forum 30, no. 1: 25. https://doi.org/10.3390/IOCAG2023-17338
APA StyleFantatto, R. R., & Pietro, R. C. L. R. (2024). Potential of Achyrocline satureioides Ethanolic Extract in the Control of Spodoptera littoralis. Biology and Life Sciences Forum, 30(1), 25. https://doi.org/10.3390/IOCAG2023-17338

